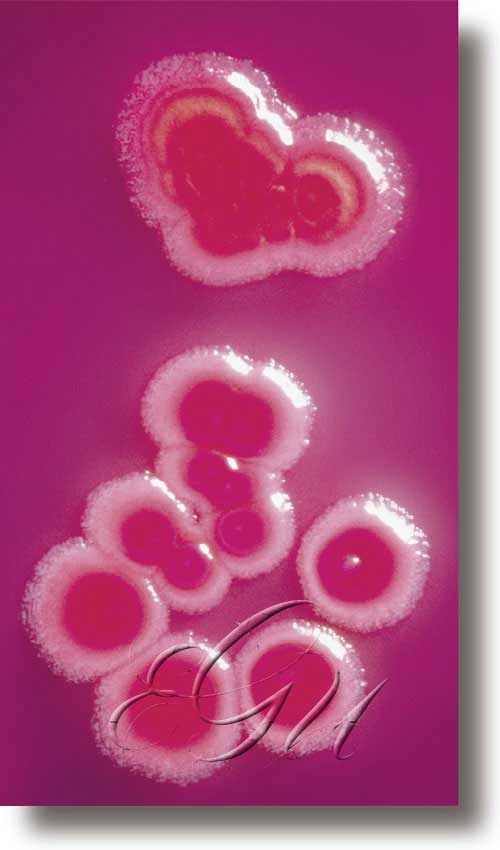

colibacilo
(
Nome co que se coñece a bacteria da especie Escherichia coli, illada por primeira vez en 1885 polo bacteriólogo alemán Theodor Escherich. É un bacilo da familia das enterobacteriáceas, curto, Gram-negativo, xeralmente móbil con cilios perítricos, que fermenta a glicosa e a lactosa con produción de gas. É hóspede habitual do tracto intestinal humano e dalgúns animais homeotermos, polo que pasa ás augas residuais mediante as feces. Eventualmente, pode contaminar as augas de consumo, por iso emprégase como organismo indicador de contaminación fecal. Algunhas cepas son patóxenas, responsables das gastroenterites infantís; outras poden selo ao atravesar a parede intestinal debilitada por algunha causa e producir infeccións xerais ou ben localizadas como infeccións urinarias ou colecistites. Pola súa gran difusión e facilidade coa que se pode manipular, o colibacilo utilízase exhaustivamente como ferramenta de traballo en investigación de bioloxía molecular, en manipulación xenética e en bioquímica e fisioloxía bacteriana.